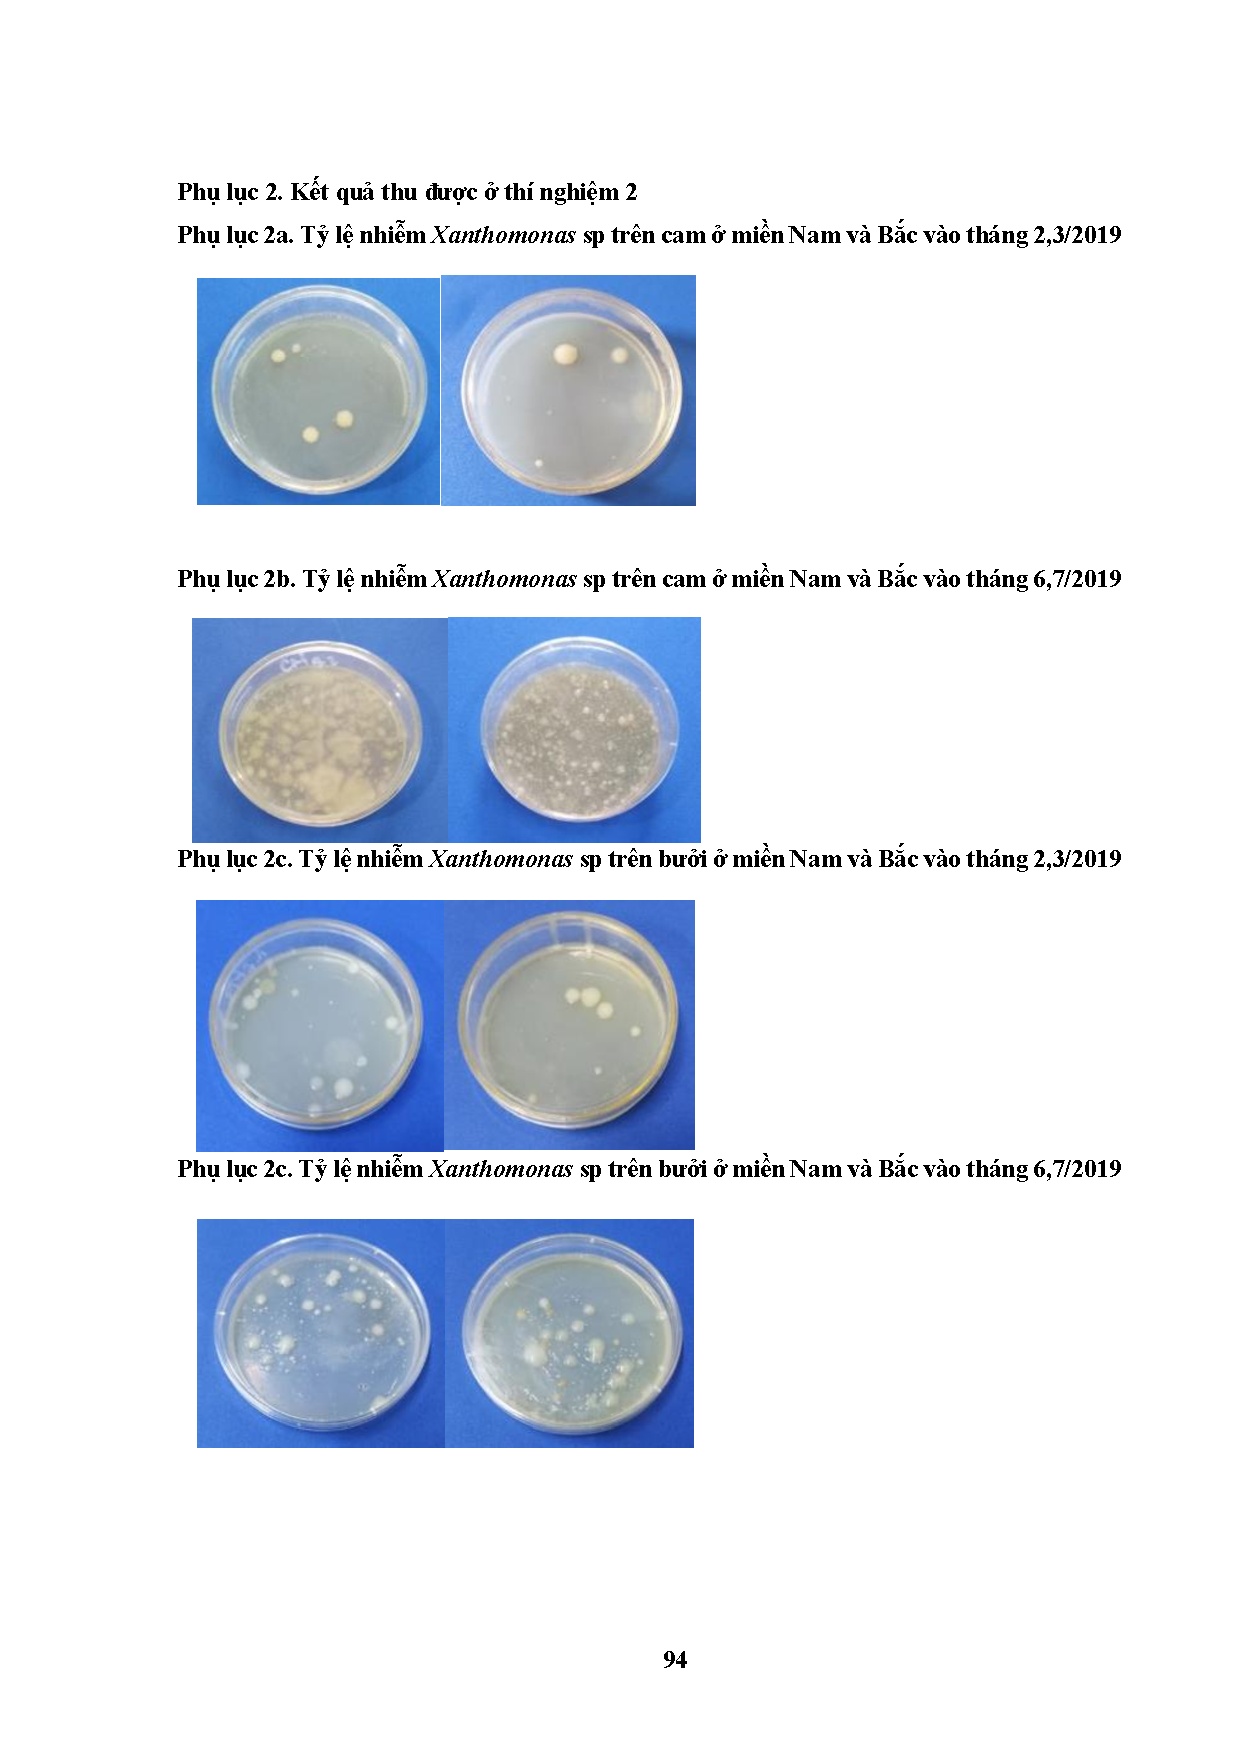
Đồ án tốt nghiệp - Nghiên cứ kết hợp các biện pháp xử lý và chiếu xạ kiểm dịch vi KGBTMQVNGBTTTQCM - Trang 124

Đồ án tốt nghiệp - Nghiên cứ kết hợp các biện pháp xử lý và chiếu xạ kiểm dịch vi KGBTMQVNGBTTTQCM
Tên môn học: Khóa luận tốt nghiệp
Giá: 90.000đ
90.000đ
Chi tiết
tài liệu :
Đồ án tốt nghiệp ngành Công nghệ thực phẩm - Nghiên cứ kết hợp các biện pháp xử lý và chiếu xạ kiểm dịch vi khuẩn gây bệnh thối mục quả và nấm gây bệnh thán thư trên quả có múi - Trường Đại học Sư phạm Kỹ thuật Thành phố Hồ Chí Minh (HCMUTE)
| Định dạng | |
| Dung lượng | 28.19 MB |
| Số trang | 166 |
| Ngành | Công nghệ thực phẩm |
| Lượt xem | 312 |
| Ngày đăng | 24/01/2026 |
TRƯỜNG ĐẠI HỌC SƯ PHẠM KỸ THUẬT THÀNH PHỐ HỒ CHÍ MINH
KHOA ĐÀO TẠO CHẤT LƯỢNG CAO
BỘ MÔN CÔNG NGHỆ THỰC PHẨM
KHÓA LUẬN TỐT NGHIỆP
MÃ SỐ: 2019 - 15116163
NGHIÊN CỨU KẾT HỢP CÁC BIỆN PHÁP XỬ
LÝ VÀ CHIẾU XẠ KIỂM DỊCH VI KHUẨN ...
KHOA ĐÀO TẠO CHẤT LƯỢNG CAO
BỘ MÔN CÔNG NGHỆ THỰC PHẨM
KHÓA LUẬN TỐT NGHIỆP
MÃ SỐ: 2019 - 15116163
NGHIÊN CỨU KẾT HỢP CÁC BIỆN PHÁP XỬ
LÝ VÀ CHIẾU XẠ KIỂM DỊCH VI KHUẨN ...
Một số trang tài liệu:

Trang 1

Trang 41

Trang 83
Trang 124

Trang 166









